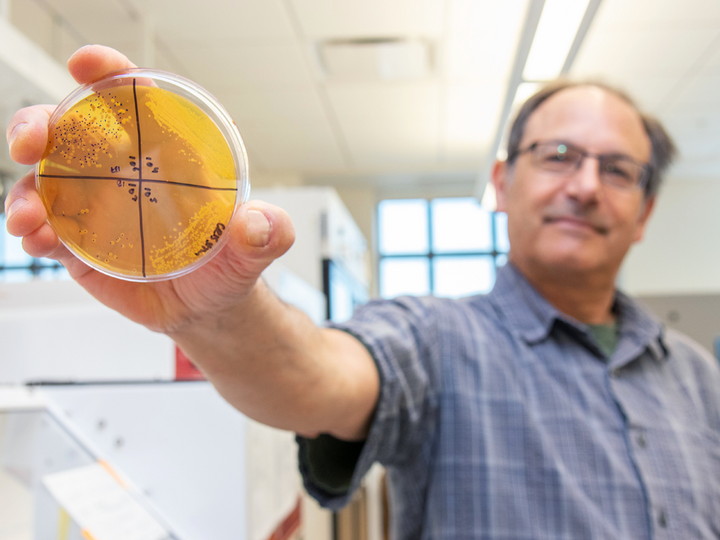

A GLOBAL LEADER
We're advancing multi-disciplinary approaches for safe, sustainable and healthy foods through innovative research, teaching and outreach.
Dr. Silvana Martini, head of the FST, discusses a $14 million dollar grant to build the bioeconomy in Nebraska and the world.
Award-Winning Faculty
36 tenure-track, research, and practice faculty. Over $2.6 million dollars in grants awarded in the last year.
World-Class Facilities
Locating in the Food Innovation Center on Nebraska's Innovation Campus, we are at the forefront of scientific innovation.
